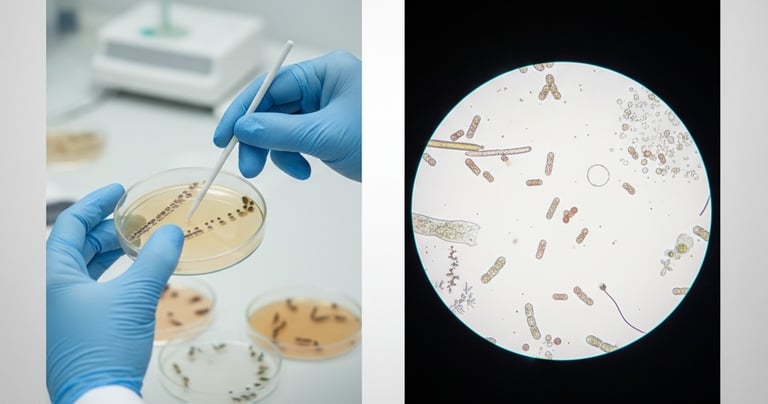
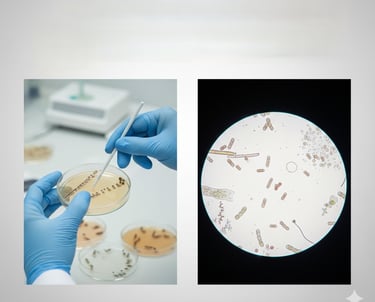

Our services
From consulting and product development to implementation and support
MSortia LLP
© 2025 MSortia LLP
M/S. MSortia LLP,
RISE (RUSA Innovation and Start up Ecosystem),
CUSATECH Foundation,
Amenity Centre, Cochin University of Science and Technology,
Cochin -682022
Powered by Mapstrix Solutions